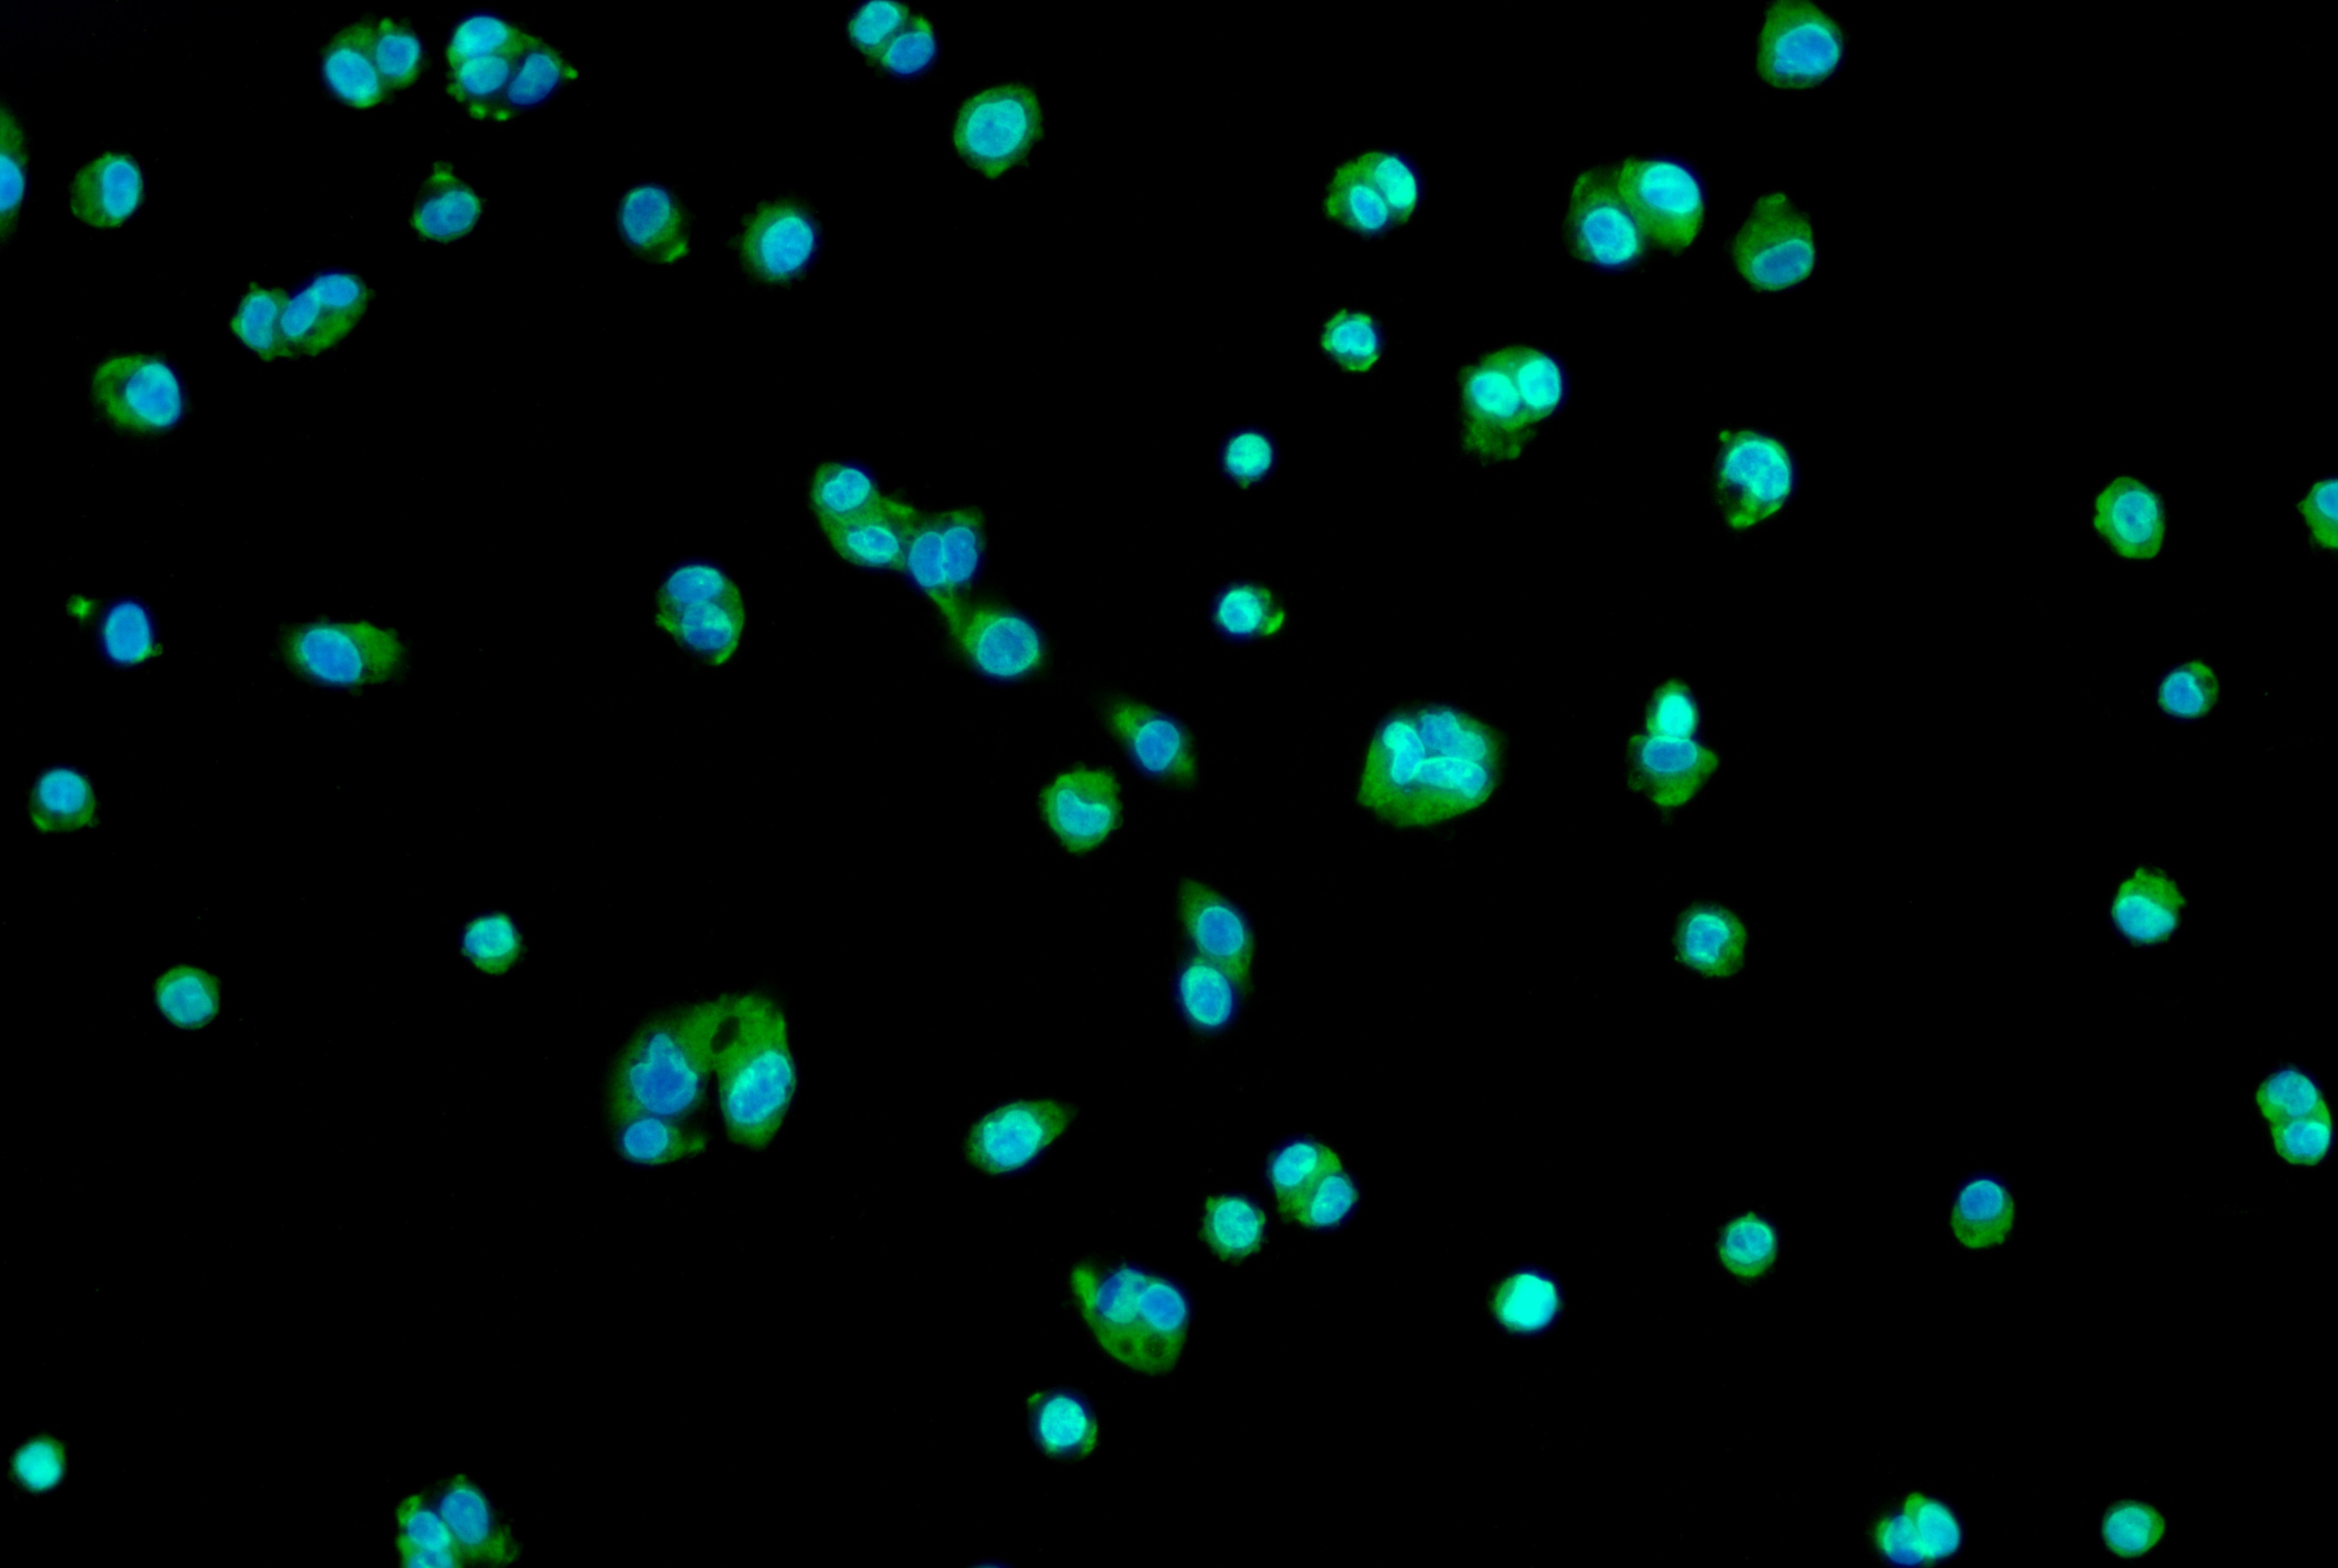

ALPP Antibody
-
中文名稱:ALPP兔多克隆抗體
-
貨號:CSB-PA001632ESR2HU
-
規(guī)格:¥440
-
圖片:
-
Western Blot
Positive WB detected in: A431 whole cell lysate(30μg), BxPC-3 whole cell lysate(30μg), Hela whole cell lysate(30μg), 293 whole cell lysate(30μg), HL60 whole cell lysate(30μg))
All lanes: ALPP antibody at 1:1000
Secondary
Goat polyclonal to rabbit IgG at 1/40000 dilution
Predicted band size: 50,66,70 kDa
Observed band size: 70 kDa
Exposure time: 120s -
Immunofluorescence staining of HepG2 cell with CSB-PA001632ESR2HU at 1:30, counter-stained with DAPI. The cells were fixed in 4% formaldehyde and blocked in 10% normal Goat Serum. The cells were then incubated with the antibody overnight at 4C. The secondary antibody was Alexa Fluor 488-congugated AffiniPure Goat Anti-Rabbit IgG(H+L).
-
Immunofluorescence staining of HepG2 cell with 5% goat serum, counter-stained with DAPI. The cells were fixed in 4% formaldehyde and blocked in 10% normal Goat Serum. The cells were then incubated with the antibody overnight at 4C. The secondary antibody was Alexa Fluor 488-congugated AffiniPure Goat Anti-Rabbit IgG(H+L).
-
-
其他:
產(chǎn)品詳情
-
產(chǎn)品名稱:Rabbit anti-Homo sapiens (Human) ALPP Polyclonal antibody
-
Uniprot No.:
-
基因名:
-
別名:ALPP; PLAP; Alkaline phosphatase, placental type; Alkaline phosphatase Regan isozyme; Placental alkaline phosphatase 1; PLAP-1
-
宿主:Rabbit
-
反應(yīng)種屬:Human
-
免疫原:Recombinant Human Alkaline phosphatase, placental type protein (260-520AA)
-
免疫原種屬:Homo sapiens (Human)
-
標記方式:Non-conjugated
-
克隆類型:Polyclonal
-
抗體亞型:IgG
-
純化方式:Antigen Affinity Purified
-
濃度:It differs from different batches. Please contact us to confirm it.
-
保存緩沖液:Preservative: 0.03% Proclin 300
Constituents: 50% Glycerol, 0.01M PBS, PH 7.4 -
產(chǎn)品提供形式:Liquid
-
應(yīng)用范圍:ELISA, WB, IF
-
推薦稀釋比:
Application Recommended Dilution WB 1:500-1:2000IF:1:20-1:100 -
Protocols:
-
儲存條件:Upon receipt, store at -20°C or -80°C. Avoid repeated freeze.
-
貨期:Basically, we can dispatch the products out in 1-3 working days after receiving your orders. Delivery time maybe differs from different purchasing way or location, please kindly consult your local distributors for specific delivery time.
-
用途:For Research Use Only. Not for use in diagnostic or therapeutic procedures.
相關(guān)產(chǎn)品
靶點詳情
-
功能:Alkaline phosphatase that can hydrolyze various phosphate compounds.
-
基因功能參考文獻:
- This meta-analysis suggests that high serum ALP level is obviously associated with lower OS rate in patients with osteosarcoma, and it is an effective biomarker of prognosis. PMID: 29970708
- Concentrations of PLAP were elevated in gingival crevicular fluid of patients with pre-eclampsia. PMID: 26988336
- SALL4 also outperformed PLAP on a small sample of cytology blocks. Although SALL4 is not entirely specific, it is a highly sensitive marker with strong diffuse nuclear reactivity in the majority of MGCTs in the posttreatment setting, at significantly higher levels than PLAP PMID: 25906119
- Quantum-mechanical computational methods were employed to study the catalytic mechanism of human placental AP (PLAP). An active-site model was used, constructed on the basis of the X-ray crystal structure of the enzyme. PMID: 25409280
- term placental explants, but not their conditioned medium, can de-phosphorylate IGFBP-1 through the action of placental alkaline phosphatase PMID: 24856042
- Anti-PLAP antibodies may serve as a modular building blocks for the development of targeted therapeutic products, armed with cytotoxic drugs, radionuclides or cytokines as payloads. PMID: 24247025
- A candidate gene, ALPP, encoding the placental alkaline phosphatase, was identified as being potentially involved in recurrent spontaneous abortion. PMID: 24296104
- The objective of the following study was to record the specificity and sensitivity of alpha5(IV) loss, smoothelin expression and PLAP expression as markers of gastrointestinal smooth muscle neoplasms PMID: 24043717
- Data indicate that p180 is required for the efficient targeting of placental alkaline phosphatase (ALPP) mRNA to the endoplasmic reticulum (ER). PMID: 24019514
- Calculation of the electrostatic potentials within the active site of human placental alkaline phosphatase also suggests that the local positive electrostatic environment may account for its capability to distinguish various substrates PMID: 21910833
- High serum alkaline phosphatase cooperating with MMP-9 is associated with metastasis in patients with primary osteosarcoma. PMID: 22333159
- PLAP exerts a positive effect on DNA replication and acts as a proliferative factor in trophoblastic cells. PMID: 21868091
- The proximity of undifferentiated gonadal tissue with the tumors as well as the immunostaining patterns (PLAP+, OCT3/4+, and CD117/KIT+) suggests that germ cells found in them are a risk factor for gonadal tumors. PMID: 21692598
- the catalytic mechanism of human placental alkaline phosphatase PMID: 21939286
- Data show that serum alkaline phosphatase, Gleason score, and intensity of bone metastasis are important and statistically significant prognostic factors, and affects time to progression and life time. PMID: 19450995
- at a certain time point during adrenocortical development, some fetal zone cells survive owing to defective apoptosis and develop into childhood ACT, maintaining some characteristics of the embryonal period, such as PLAP expression PMID: 21516013
- Serum total calcium (r -0.1362, p<0.001), serum inorganic phosphate (r -0.45, p<0.001) and serum alkaline phosphatase (r -0.5587, p<0.001) have shown inverse relationship with age. PMID: 20655896
- High serum alkaline phosphatase is associated with chronic kidney disease. PMID: 20299338
- differential expression of Pl(1) and Pl(2) probably results from linkage disequilibrium with the sequence variation rs2014683G>A in the ALPP gene promoter that was shown to have allele-specific binding patterns to placental nuclear proteins. PMID: 20663553
- structure of placental alkaline phosphatase with pNPP contained only p-nitrophenol in three distinct sites, while the structure with 5'-AMP contained the p-nitrophenyl group in two of the sites instead of 5'-AMP PMID: 20693656
- Low magnitudes of tensile strain enhance expression of alkaline phosphatase in human osteoblasts. PMID: 19595020
- The PLAP D allele contains two amino acid substitutions: P209R (692C>G) and E429G (1352 A>G). PMID: 11857742
- Proximity of the protein moiety of a GPI-anchored protein to the membrane surface: a FRET study. PMID: 12081485
- the beta-N-acetylglucosaminyl phosphate diester residue is attached to the glycosylphosphatidylinositol anchor of human placental alkaline phosphatase and is a target of the channel-forming toxin aerolysin PMID: 12851398
- receptor for Aeromonas sobria hemolysin. PMID: 15715171
- analysis of human placental alkaline phosphatase in complex with functional ligands PMID: 15946677
- The effect of parity on placental weight and birth weight is examined through a series of birth records from an Indian population in Calcutta. PMID: 16431676
- crystal structure of strontium-substituted human placental alkaline phosphatase shows that strontium substitutes the calcium ion with concomitant modification of the metal coordination PMID: 16815919
- activity of GPI-anchored enzymes may be modulated by membrane microenvironment features PMID: 18416535
- Serum bilirubin, alkaline phosphatase, and aspartate aminotransferase are an efficient set of biochemistries to identify UDCA-treated patients with primary biliary cirrhosis at risk of death or liver transplantation (LT). PMID: 18752324
- Elevations of alkaline phosphatase is associated with therapy related pediatric cancer. PMID: 18802949
顯示更多
收起更多
-
亞細胞定位:Cell membrane; Lipid-anchor, GPI-anchor.
-
蛋白家族:Alkaline phosphatase family
-
組織特異性:Detected in placenta (at protein level).
-
數(shù)據(jù)庫鏈接:
Most popular with customers
-
-
Phospho-YAP1 (S127) Recombinant Monoclonal Antibody
Applications: ELISA, WB, IHC
Species Reactivity: Human
-
-
-
-
-
-